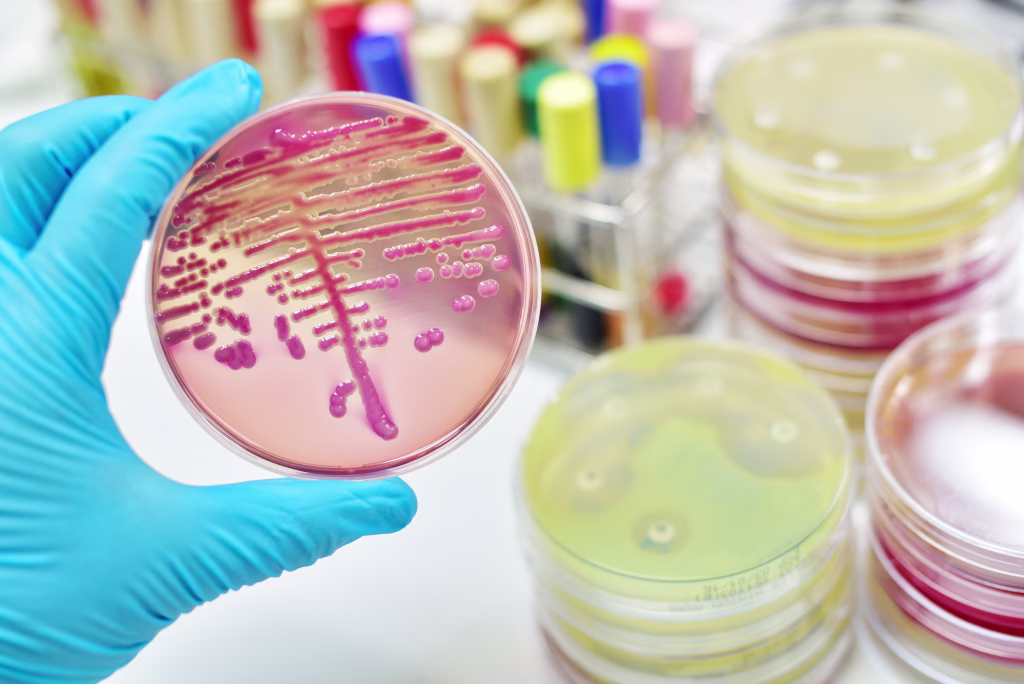
Colony of bacteria in culture medium plate

Med raziskovanjem znanega antibiotika so znanstveniki povsem nepričakovano naleteli na spojino, ki kaže izjemen potencial v boju proti najnevarnejšim večkratno odpornim bakterijam. Nova spojina, imenovana pre-metilenomicin C lakton, bi lahko pomenila začetek nove generacije antibiotikov – in kar je najpomembneje, ne povzroča razvoja odpornosti.
Nepričakovano odkritje med proučevanjem starega antibiotika
Znanstvenika Lona Alkhalaf in Greg Challis iz Združenega kraljestva sta s svojo ekipo raziskovala, kako bakterija Streptomyces coelicolor proizvaja znani antibiotik metilenomicin A. Namesto novega zdravila so sprva iskali razumevanje bioloških poti, ki vodijo do tvorbe te spojine. Vendar jih je prav ta raziskovalna pot pripeljala do pomembnega odkritja.
Z odstranjevanjem določenih genov iz t. i. biosintetskih genskih grozdov so uspeli začasno zaustaviti kemične reakcije v mikroorganizmu. Na tej točki so identificirali dve doslej še neznani spojini: pre-metilenomicin C in pre-metilenomicin C lakton. Nadaljnja analiza je pokazala, da ima slednja izjemno močan protibakterijski učinek. »Spojina je aktivna proti številnim Gram-pozitivnim bakterijam, vključno z meticilin-rezistentnim Staphylococcus aureus (MRSA) in večkratno odporno obliko Enterococcus faecium,« sta pojasnila Alkhalaf in Challis.
Stokrat močnejši in bakterije ne razvijejo odpornosti
V laboratorijskih testih na različnih bakterijskih sevih je pre-metilenomicin C lakton pokazal do 100-krat večjo učinkovitost kot izvorni antibiotik. A še bolj pomembno je, da bakterije v 28-dnevnem eksperimentu niso razvile nikakršne odpornosti nanj. To je ena največjih težav sodobne medicine – dolgotrajna izpostavljenost bakterij antibiotikom pogosto vodi v razvoj odpornosti, kar lahko običajne okužbe spremeni v življenjsko nevarna stanja.
V omenjenem poskusu so bakterije E. faecium izpostavljali vse višjim koncentracijam spojine, vendar minimalna zaviralna koncentracija (MIC) ni pokazala sprememb, kar pomeni, da bakterije niso razvile obrambnih mehanizmov. »To je res lepa študija in pomembna lekcija: če izolirate nove spojine, iščite tudi nove učinke,« je komentiral Stephen Cochrane, medicinski kemik z univerze Queen’s University Belfast, ki v študiji ni sodeloval.

Zakaj je to odkritje še posebej pomembno
V zadnjih desetletjih se je razvoj novih antibiotikov močno upočasnil. Zaradi visokih stroškov, zapletenih postopkov razvoja in nizke ekonomske donosnosti farmacevtska podjetja redko vlagajo v raziskave novih protimikrobnih zdravil. Po podatkih Svetovne zdravstvene organizacije se odpornost bakterij na obstoječe antibiotike hitro širi, kar ogroža zmožnost zdravljenja osnovnih okužb in rutinskih kirurških posegov.
Do leta 2050 bi lahko zaradi odpornosti na antibiotike umrlo do 10 milijonov ljudi letno, če ne bo razvito dovolj novih učinkovin. Prav zato je vsako novo odkritje, ki obeta visoko učinkovitost brez razvoja odpornosti, izjemnega pomena za globalno javno zdravje.
Pot do zdravila je še dolga, a obetavna
Kljub obetavnim rezultatom znanstveniki opozarjajo, da je pot do dejanskega zdravila šele na začetku. Potrebno bo razviti sintetični način pridobivanja spojine v večjih količinah, preveriti njeno varnost pri ljudeh ter preučiti vpliv na različne celične tarče.
Zato so se raziskovalci povezali s kemikom Davidom Luptonom z univerze Monash v Avstraliji, da bi razvili kemično sintezo pre-metilenomicin C laktona. Cilj je omogočiti proizvodnjo večjih količin za nadaljnje klinične in toksikološke raziskave. »Koristno bi bilo identificirati biološke tarče spojine pri občutljivih bakterijah in razumeti, kako spremembe v strukturi vplivajo na vezavo in biološko aktivnost,« sta pojasnila Alkhalaf in Challis.

Nova fronta v boju proti superbakterijam
Odporne bakterije so eden največjih izzivov sodobne medicine. Odkritje pre-metilenomicin C laktona bi lahko pomenilo nov preboj v iskanju antibiotikov, ki so hkrati učinkoviti, varni in dolgotrajno uporabni. Če bodo nadaljnje študije potrdile prvotne rezultate, se nam morda obeta zdravilo, ki bo učinkovito tudi tam, kjer drugi antibiotiki odpovejo.
Novinar




